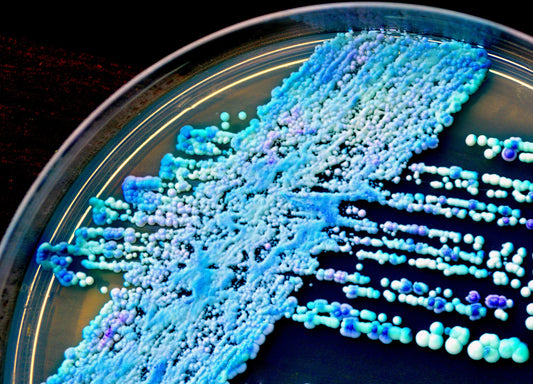

Articles

Finding the Right Enzyme Science Digestive Form...
Many people deal with occasional gastrointestinal issues, as well as a variety of other health issues. Incorporating digestive enzymes in the care of the naturopathic patient can support digestive health...
Finding the Right Enzyme Science Digestive Form...
Many people deal with occasional gastrointestinal issues, as well as a variety of other health issues. Incorporating digestive enzymes in the care of the naturopathic patient can support digestive health...

Digesting Fatty Foods with Lipase
Lipase Function Like many other enzymes, lipase is produced naturally by the body, in this case, in the pancreas. When you eat foods with fat content, the fat can’t be...
Digesting Fatty Foods with Lipase
Lipase Function Like many other enzymes, lipase is produced naturally by the body, in this case, in the pancreas. When you eat foods with fat content, the fat can’t be...

What is Protease?
October 3rd, 2018 The Importance of Protein Protein is generally hailed as one of the “building blocks” of the human body, being an essential component in many bodily structures as well...
What is Protease?
October 3rd, 2018 The Importance of Protein Protein is generally hailed as one of the “building blocks” of the human body, being an essential component in many bodily structures as well...
The Unique Candidase Pro Formulation
The natural ingredients in Candida Control™ help in maintaining a healthy balance of intestinal flora, which inhibits Candida overgrowth.* This scientifically formulated blend of carefully selected ingredients can help break...
The Unique Candidase Pro Formulation
The natural ingredients in Candida Control™ help in maintaining a healthy balance of intestinal flora, which inhibits Candida overgrowth.* This scientifically formulated blend of carefully selected ingredients can help break...

New Study: Nattokinase for Nasal Polyps and as ...
Chronic nasal and sinus inflammation or chronic rhinosinusitis (CRS) is is one of the most common chronic diseases in adults. It is characterized by persistent symptomatic inflammation of the nasal...
New Study: Nattokinase for Nasal Polyps and as ...
Chronic nasal and sinus inflammation or chronic rhinosinusitis (CRS) is is one of the most common chronic diseases in adults. It is characterized by persistent symptomatic inflammation of the nasal...

Choosing Enzymes for Your Practice
Practitioners often ask us, “What should I look for when choosing enzyme products for my practice?” This blog aims to succinctly answer that question, but first encourages you to identify...
Choosing Enzymes for Your Practice
Practitioners often ask us, “What should I look for when choosing enzyme products for my practice?” This blog aims to succinctly answer that question, but first encourages you to identify...

